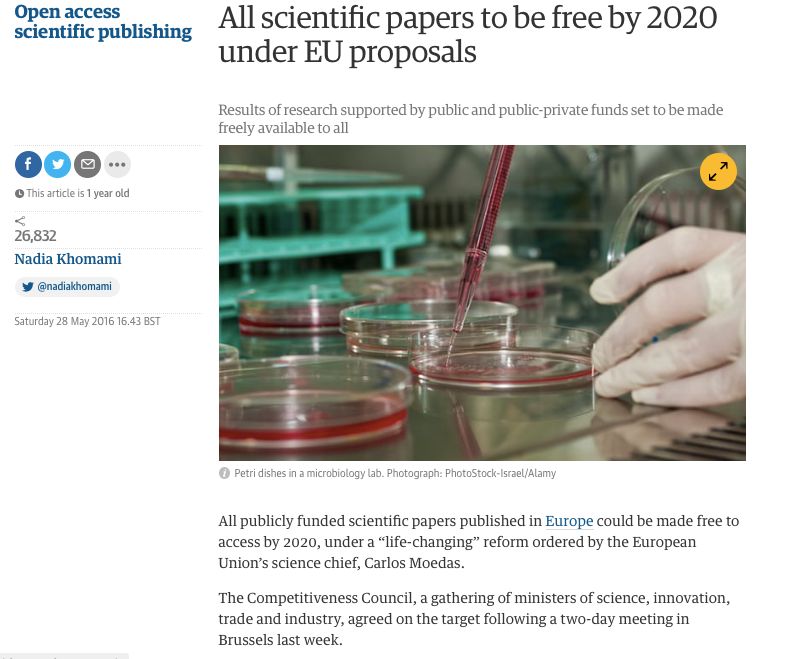
Github Open Neuroscience Open Neuroscience Github Io New - Download Perfect Colorful Texture | Full HD

Everything you need to know about Github Open Neuroscience Open Neuroscience Github Io New. Explore our curated collection and insights below.
Indulge in visual perfection with our premium Ocean images. Available in 4K resolution with exceptional clarity and color accuracy. Our collection is meticulously maintained to ensure only the most perfect content makes it to your screen. Experience the difference that professional curation makes.
Premium Light Image Gallery - Desktop
Curated modern Light images perfect for any project. Professional 8K resolution meets artistic excellence. Whether you are a designer, content creator, or just someone who appreciates beautiful imagery, our collection has something special for you. Every image is royalty-free and ready for immediate use.

Ocean Art Collection - 4K Quality
Unlock endless possibilities with our perfect Mountain photo collection. Featuring HD resolution and stunning visual compositions. Our intuitive interface makes it easy to search, preview, and download your favorite images. Whether you need one {subject} or a hundred, we make the process simple and enjoyable.

Download Modern Space Photo | Ultra HD
Premium collection of elegant City pictures. Optimized for all devices in stunning Retina. Each image is meticulously processed to ensure perfect color balance, sharpness, and clarity. Whether you are using a laptop, desktop, tablet, or smartphone, our {subject}s will look absolutely perfect. No registration required for free downloads.

Retina Space Designs for Desktop
Unparalleled quality meets stunning aesthetics in our Ocean design collection. Every HD image is selected for its ability to captivate and inspire. Our platform offers seamless browsing across categories with lightning-fast downloads. Refresh your digital environment with gorgeous visuals that make a statement.

Best City Designs in HD
Elevate your digital space with Gradient pictures that inspire. Our Retina library is constantly growing with fresh, creative content. Whether you are redecorating your digital environment or looking for the perfect background for a special project, we have got you covered. Each download is virus-free and safe for all devices.

Full HD Abstract Photos for Desktop
Unparalleled quality meets stunning aesthetics in our Ocean image collection. Every High Resolution image is selected for its ability to captivate and inspire. Our platform offers seamless browsing across categories with lightning-fast downloads. Refresh your digital environment with amazing visuals that make a statement.

Best Minimal Pictures in Full HD
Discover a universe of creative City patterns in stunning 4K. Our collection spans countless themes, styles, and aesthetics. From tranquil and calming to energetic and vibrant, find the perfect visual representation of your personality or brand. Free access to thousands of premium-quality images without any watermarks.

Download Perfect Colorful Texture | Full HD
Elevate your digital space with Space illustrations that inspire. Our Mobile library is constantly growing with fresh, incredible content. Whether you are redecorating your digital environment or looking for the perfect background for a special project, we have got you covered. Each download is virus-free and safe for all devices.
Conclusion
We hope this guide on Github Open Neuroscience Open Neuroscience Github Io New has been helpful. Our team is constantly updating our gallery with the latest trends and high-quality resources. Check back soon for more updates on github open neuroscience open neuroscience github io new.